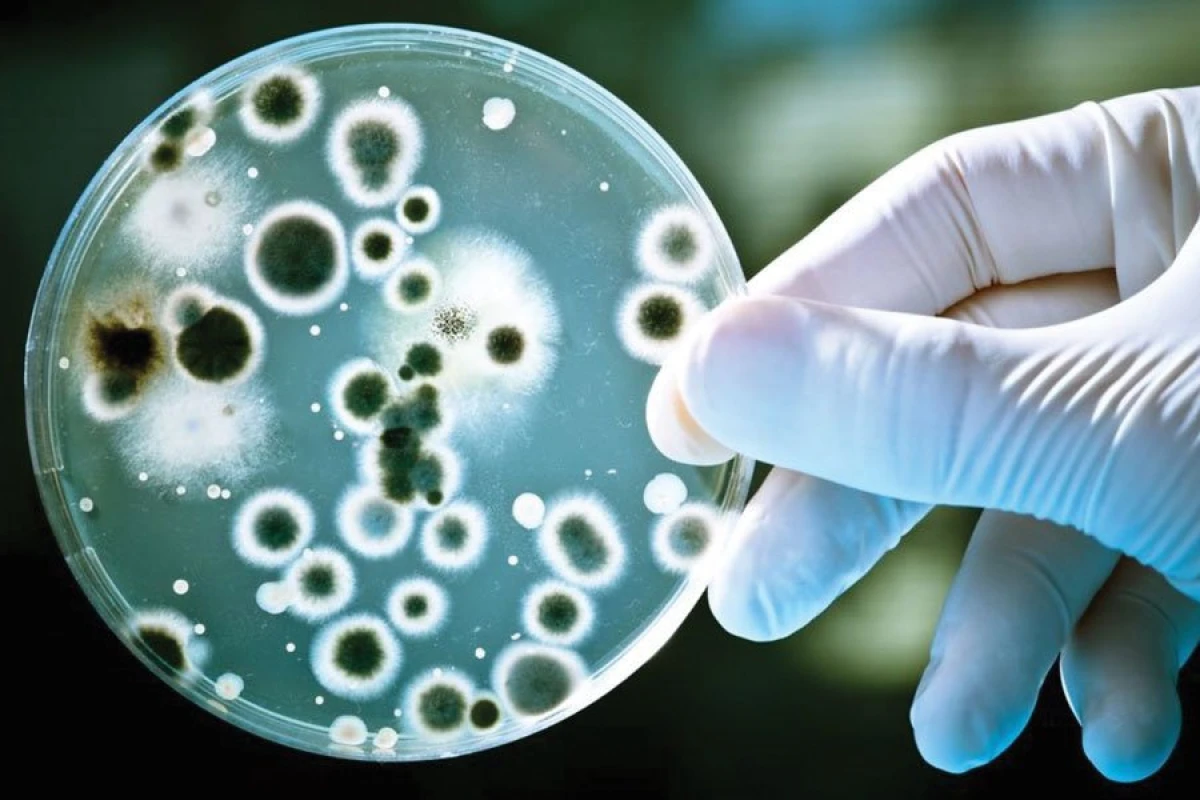

Американские ученые обнаружили в организме каждого третьего пациента из клиник Хьюстона ранее неизвестный штамм супербактерий, стойких к действию почти всех антибиотиков. Геном бактерий был опубликован в журнале mBio.
В ходе исследования ученые изучили 1700 разновидностей штаммов пневмококка, которые были найдены в организме больных жителей штата Техас за четыре года. Это исследование раскрыло тревожный тренд – примерно треть посетителей госпиталей Хьюстона оказались носителями ранее неизученного штамма CG307, способного синтезировать "противоядия" фактически ко всем антибиотикам "последней надежды".
Эти микробы начали появляться в клиниках штата в 2015 году, и их доля в популяции больничных микробов сегодня продолжает быстро расти. Эти микробы, как показал анализ их ДНК и белков, научились синтезировать особые ферменты – так называемые металл-бета-лактамазы (МБЛ), способные "ловить" и нейтрализовать молекулы самых мощных антибиотиков из класса карбапенемов. Благодаря этому микроб является фактически неуязвимым к действию лекарств, и у ученых пока нет эффективных способов борьбы с ними, помимо очищения зараженных тканей тела и сред обитания от ионов цинка, необходимых для работы МБЛ-ферментов.
Это объединяет их с другим особо опасным видом "супермикробов", найденным три года назад в канализациях Нью-Дели, столице Индии. Данные бактерии, как тогда выяснили ученые, научились защищать не только себя от антибиотиков, но и других микробов, вырабатывая особые "пузырьки", начиненные белками, нейтрализующими молекулы лекарства.
Джерело – Вгору








